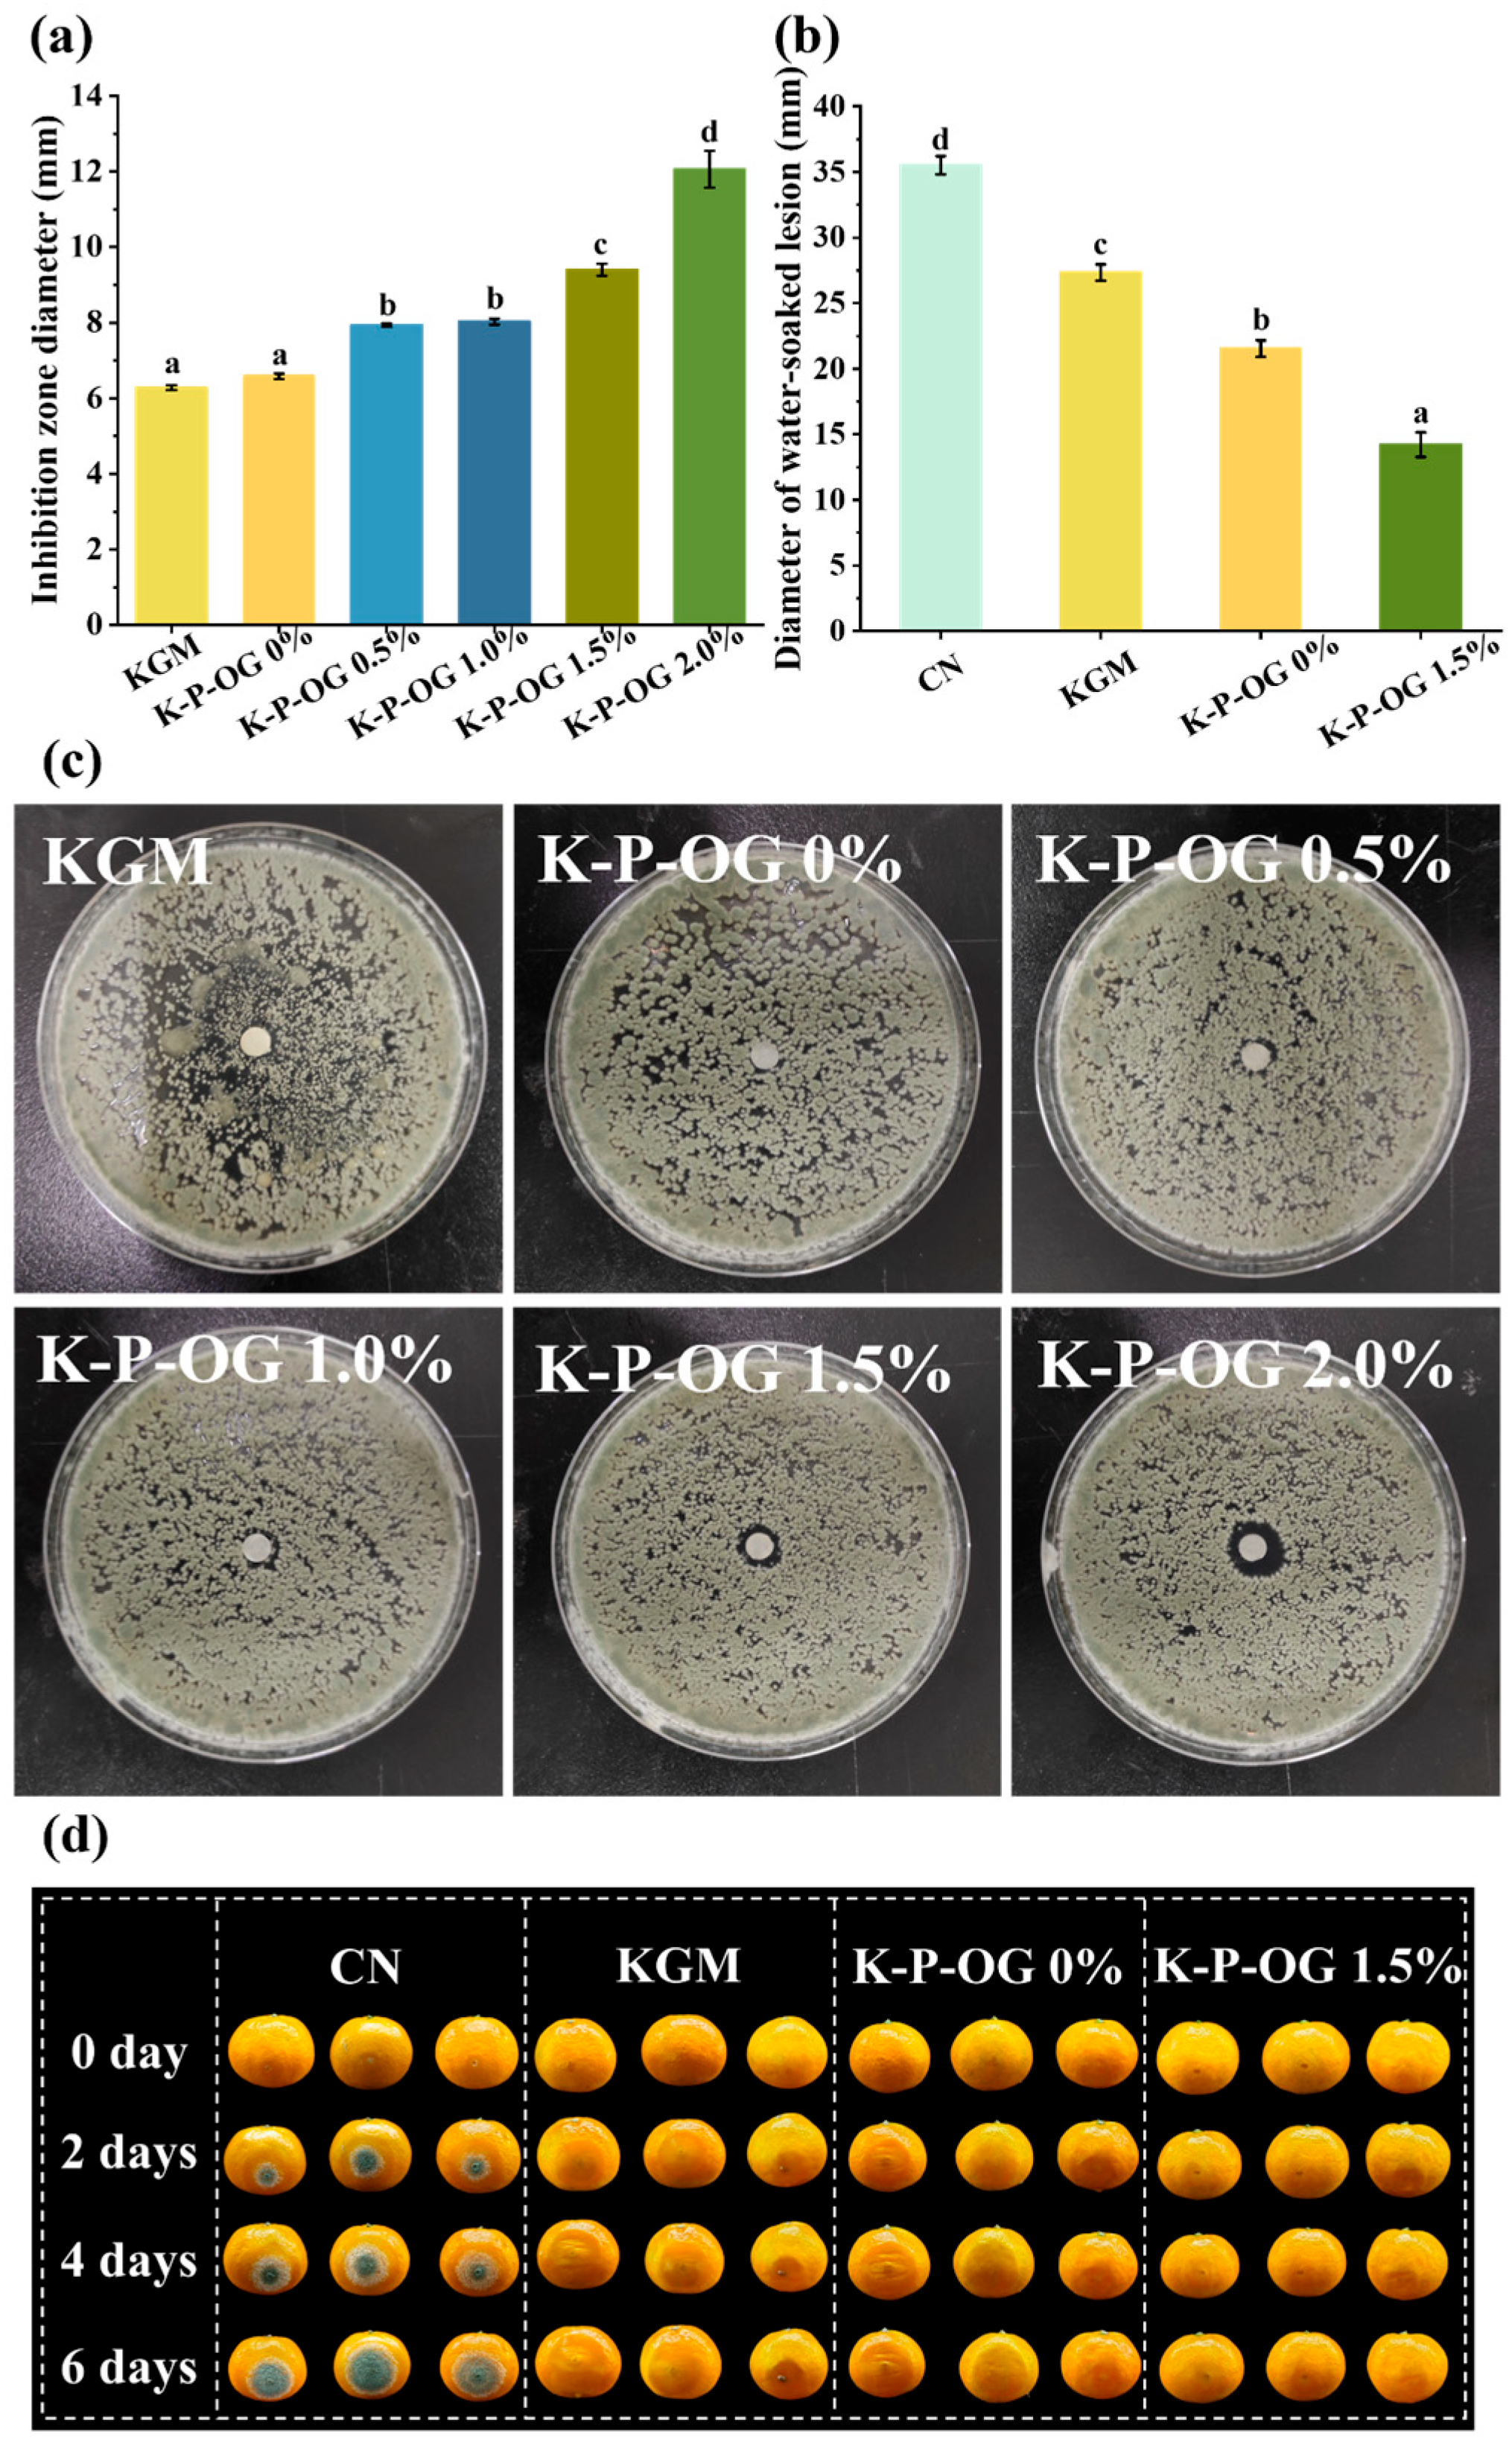
Polymers 17 01217 g009

Edible Coating Based on Konjac glucomannan Loading Ocimum gratissimum Essential Oil for Postharvest Preservation of Orange
Abstract
1. Introduction
2. Materials and Methods
2.1. Materials
2.2. Fabrication of KGM-Based Coating
2.3. Characterization of Coating Solutions
2.3.1. Stability
2.3.2. Apparent Viscosity
2.3.3. Scanning Electron Microscope (SEM)
2.3.4. Air Barrier Property
2.3.5. Wetting
2.3.6. Release of OG in the Coating
2.4. Antioxidant Activity, In Vitro and In Vivo Antifungal Activity Assay
2.5. Preservation Effect on Mandarin orange
2.5.1. Coating Treatment of Mandarin oranges
2.5.2. Weight Loss and Firmness
2.5.3. Total Solid Content and Total Acid
2.5.4. Vitamin C Content
2.5.5. Peroxidase
2.5.6. Decay Rate
3. Results
3.1. Stability of the Coating Solutions
3.2. Apparent Viscosity Analysis
3.3. SEM
3.4. Air Barrier Properties
3.5. Wetting Property
3.6. The Release Performance of OG from the Coating
3.7. Antioxidant Activity
3.8. In Vitro and In Vivo Antifungal Test
3.9. Preservation Effect
4. Conclusions
Author Contributions
Funding
Institutional Review Board Statement
Data Availability Statement
Acknowledgments
Conflicts of Interest
References
- Nekvapil, F.; Brezestean, I.; Barchewitz, D.; Glamuzina, B.; Chiş, V.; Cintă Pinzaru, S. Citrus fruits freshness assessment using Raman spectroscopy. Food Chem. 2018, 242, 560–567. [Google Scholar] [CrossRef] [PubMed]
- Cheng, X.; Yang, Y.; Zhu, X.; Yuan, P.; Gong, B.; Ding, S.; Shan, Y. Inhibitory mechanisms of cinnamic acid on the growth of Geotrichum citri-aurantii. Food Control 2022, 131, 108459. [Google Scholar] [CrossRef]
- You, Y.; Zhou, Y.; Duan, X.; Mao, X.; Li, Y. Research progress on the application of different preservation methods for controlling fungi and toxins in fruit and vegetable. Crit. Rev. Food Sci. Nutr. 2023, 63, 12441–12452. [Google Scholar] [CrossRef] [PubMed]
- Panahirad, S.; Dadpour, M.; Peighambardoust, S.H.; Soltanzadeh, M.; Gullón, B.; Alirezalu, K.; Lorenzo, J.M. Applications of carboxymethyl cellulose- and pectin-based active edible coatings in preservation of fruits and vegetables: A review. Trends Food Sci. Technol. 2021, 110, 663–673. [Google Scholar] [CrossRef]
- Riva, S.C.; Opara, U.O.; Fawole, O.A. Recent developments on postharvest application of edible coatings on stone fruit: A review. Sci. Hortic. 2020, 262, 109074. [Google Scholar] [CrossRef]
- Hassan, B.; Chatha, S.A.S.; Hussain, A.I.; Zia, K.M.; Akhtar, N. Recent advances on polysaccharides, lipids and protein based edible films and coatings: A review. Int. J. Biol. Macromol. 2018, 109, 1095–1107. [Google Scholar] [CrossRef]
- Cazón, P.; Velazquez, G.; Ramírez, J.A.; Vázquez, M. Polysaccharide-based films and coatings for food packaging: A review. Food Hydrocoll. 2017, 68, 136–148. [Google Scholar] [CrossRef]
- Atta, O.M.; Manan, S.; Shahzad, A.; Ul-Islam, M.; Ullah, M.W.; Yang, G. Biobased materials for active food packaging: A review. Food Hydrocoll. 2022, 125, 107419. [Google Scholar] [CrossRef]
- Nian, L.; Wang, M.; Sun, X.; Zeng, Y.; Xie, Y.; Cheng, S.; Cao, C. Biodegradable active packaging: Components, preparation, and applications in the preservation of postharvest perishable fruits and vegetables. Crit. Rev. Food Sci. Nutr. 2022, 64, 2304–2339. [Google Scholar] [CrossRef]
- Ni, Y.; Liu, Y.; Zhang, W.; Shi, S.; Zhu, W.; Wang, R.; Zhang, L.; Chen, L.; Sun, J.; Pang, J.; et al. Advanced konjac glucomannan-based films in food packaging: Classification, preparation, formation mechanism and function. LWT 2021, 152, 112338. [Google Scholar] [CrossRef]
- Liu, Z.; Lin, D.; Shen, R.; Yang, X. Characterizations of novel konjac glucomannan emulsion films incorporated with high internal phase Pickering emulsions. Food Hydrocoll. 2020, 109, 106088. [Google Scholar] [CrossRef]
- Xu, J.; He, M.; Wei, C.; Duan, M.; Yu, S.; Li, D.; Zhong, W.; Tong, C.; Pang, J.; Wu, C. Konjac glucomannan films with Pickering emulsion stabilized by TEMPO-oxidized chitin nanocrystal for active food packaging. Food Hydrocoll. 2023, 139, 108539. [Google Scholar] [CrossRef]
- Dambolena, J.S.; Zunino, M.P.; López, A.G.; Rubinstein, H.R.; Zygadlo, J.A.; Mwangi, J.W.; Thoithi, G.N.; Kibwage, I.O.; Mwalukumbi, J.M.; Kariuki, S.T. Essential oils composition of Ocimum basilicum L. and Ocimum gratissimum L. from Kenya and their inhibitory effects on growth and fumonisin production by Fusarium verticillioides. Innov. Food Sci. Emerg. Technol. 2010, 11, 410–414. [Google Scholar] [CrossRef]
- Xiao, W.; Guo, J.; Fu, Y.; Li, Z.; Zhang, T.; He, M.; Liu, T.; Xiao, Y.; Shang, X.; Fu, F.; et al. Long-term study of Citrus changshan-huyou Y.B. Chang essential oil: Chemical transformations and their impact on antibacterial efficacy. Food Chem. 2025, 474, 143118. [Google Scholar] [CrossRef]
- Kačániová, M.; Galovičová, L.; Borotová, P.; Valková, V.; Ďúranová, H.; Kowalczewski, P.Ł.; Ahl, H.A.H.S.-A.; Hikal, W.M.; Vukic, M.; Savitskaya, T.; et al. Chemical Composition, In Vitro and In Situ Antimicrobial and Antibiofilm Activities of Syzygium aromaticum (Clove) Essential Oil. Plants 2021, 10, 2185. [Google Scholar] [CrossRef]
- Reis, D.R.; Ambrosi, A.; Luccio, M.D. Encapsulated essential oils: A perspective in food preservation. Future Foods 2022, 5, 100126. [Google Scholar] [CrossRef]
- Jia, Y.; Khalifa, I.; Dang, M.; Zhang, Y.; Zhu, L.; Zhao, M.; Li, K.; Li, C. Confirmation and understanding the potential emulsifying characterization of persimmon pectin: From structural to diverse rheological aspects. Food Hydrocoll. 2022, 131, 107738. [Google Scholar] [CrossRef]
- Lei, Y.; Wu, H.; Jiao, C.; Jiang, Y.; Liu, R.; Xiao, D.; Lu, J.; Zhang, Z.; Shen, G.; Li, S. Investigation of the structural and physical properties, antioxidant and antimicrobial activity of pectin-konjac glucomannan composite edible films incorporated with tea polyphenol. Food Hydrocoll. 2019, 94, 128–135. [Google Scholar] [CrossRef]
- Liu, Y.; Cheng, Y.; Yu, X.; Zhu, J.; Chen, K.; Kuang, Y.; Wu, K.; Jiang, F. Konjac glucomannan films incorporated pectin-stabilized Mandarin oil emulsions: Structure, properties, and application in fruit preservation. Int. J. Biol. Macromol. 2024, 267, 131292. [Google Scholar] [CrossRef]
- Xu, T.; Gao, C.; Feng, X.; Huang, M.; Yang, Y.; Shen, X.; Tang, X. Cinnamon and clove essential oils to improve physical, thermal and antimicrobial properties of chitosan-gum arabic polyelectrolyte complexed films. Carbohydr. Polym. 2019, 217, 116–125. [Google Scholar] [CrossRef]
- Jouki, M.; Yazdi, F.T.; Mortazavi, S.A.; Koocheki, A. Quince seed mucilage films incorporated with oregano essential oil: Physical, thermal, barrier, antioxidant and antibacterial properties. Food Hydrocoll. 2014, 36, 9–19. [Google Scholar] [CrossRef]
- Wang, T.; Yang, Z.; Zhang, C.; Zhai, X.; Zhang, X.; Huang, X.; Li, Z.; Zhang, X.; Zou, X.; Shi, J. Chitosan-cinnamon essential oil/sodium alginate-TiO2 bilayer films with enhanced bioactive retention property: Application for mango preservation. Int. J. Biol. Macromol. 2022, 222, 2843–2854. [Google Scholar] [CrossRef] [PubMed]
- Chen, C.; Chen, J.; Wan, C. Pinocembrin-7-Glucoside (P7G) reduced postharvest blue mold of navel orange by suppressing Penicillium italicum growth. Microorganisms 2020, 8, 536. [Google Scholar] [CrossRef]
- Da Silva, T.; Aguiar-Oliveira, E.; Mazalli, M.R.; Kamimura, E.S.; Maldonado, R.R. Comparison between titrimetric and spectrophotometric methods for quantification of vitamin C. Food Chem. 2017, 224, 92–96. [Google Scholar] [CrossRef] [PubMed]
- Gao, Y.; Kan, C.; Wan, C.; Chen, C.; Chen, M.; Chen, J. Quality and biochemical changes of navel orange fruits during storage as affected by cinnamaldehyde-chitosan coating. Sci. Hortic. 2018, 239, 80–86. [Google Scholar] [CrossRef]
- Makarova, E.N.; Shakhmatov, E.G. Covalently linked pectin-arabinoglucuronoxylan complex from Siberian fir Abies sibirica Ledeb. Carbohydr. Polym. 2022, 277, 118832. [Google Scholar] [CrossRef]
- Liang, W.-l.; Liao, J.-s.; Qi, J.-R.; Jiang, W.-x.; Yang, X.-q. Physicochemical characteristics and functional properties of high methoxyl pectin with different degree of esterification. Food Chem. 2022, 375, 131806. [Google Scholar] [CrossRef]
- Luo, S.-Z.; Hu, X.-F.; Jia, Y.-J.; Pan, L.-H.; Zheng, Z.; Zhao, Y.-Y.; Mu, D.-D.; Zhong, X.-Y.; Jiang, S.-T. Camellia oil-based oleogels structuring with tea polyphenol-palmitate particles and citrus pectin by emulsion-templated method: Preparation, characterization and potential application. Food Hydrocoll. 2019, 95, 76–87. [Google Scholar] [CrossRef]
- Salim, D.; de Caro, P.; Chasseray, X.; Cheong Sing, A.S. Development of biobased emulsions for postharvest citrus fruit preservation. Sustain. Chem. Pharm. 2022, 25, 100583. [Google Scholar] [CrossRef]
- Wu, H.; Wu, H.; Qing, Y.; Wu, C.; Pang, J. KGM/chitosan bio-nanocomposite films reinforced with ZNPs: Colloidal, physical, mechanical and structural attributes. Food Packag. Shelf Life 2022, 33, 100870. [Google Scholar] [CrossRef]
- Zhang, S.; He, Z.; Xu, F.; Cheng, Y.; Waterhouse, G.I.N.; Sun-Waterhouse, D.; Wu, P. Enhancing the performance of konjac glucomannan films through incorporating zein–pectin nanoparticle-stabilized oregano essential oil Pickering emulsions. Food Hydrocoll. 2022, 124, 107222. [Google Scholar] [CrossRef]
- Zhou, Q.; Huang, S.; Zou, L.; Ren, D.; Wu, X.; Xu, D. Application of hydroxypropyl methylcellulose to improve the wettability of chitosan coating and its preservation performance on tangerine fruits. Int. J. Biol. Macromol. 2024, 263, 130539. [Google Scholar] [CrossRef]
- Liu, Z.; Lin, D.; Shen, R.; Zhang, R.; Liu, L.; Yang, X. Konjac glucomannan-based edible films loaded with thyme essential oil: Physical properties and antioxidant-antibacterial activities. Food Packag. Shelf Life 2021, 29, 100700. [Google Scholar] [CrossRef]
- Kowalczyk, D.; Gustaw, W.; Zięba, E.; Lisiecki, S.; Stadnik, J.; Baraniak, B. Microstructure and functional properties of sorbitol-plasticized pea protein isolate emulsion films: Effect of lipid type and concentration. Food Hydrocoll. 2016, 60, 353–363. [Google Scholar] [CrossRef]
- Guo, Z.; Ge, X.; Li, W.; Yang, L.; Han, L.; Yu, Q.-l. Active-intelligent film based on pectin from watermelon peel containing beetroot extract to monitor the freshness of packaged chilled beef. Food Hydrocoll. 2021, 119, 106751. [Google Scholar] [CrossRef]
- Valenzuela, C.; Abugoch, L.; Tapia, C. Quinoa protein–chitosan–sunflower oil edible film: Mechanical, barrier and structural properties. LWT-Food Sci. Technol. 2013, 50, 531–537. [Google Scholar] [CrossRef]
- Bhatia, S.; Al-Harrasi, A.; Al-Azri, M.S.; Ullah, S.; Bekhit, A.E.; Pratap-Singh, A.; Chatli, M.K.; Anwer, K.; Aldawsari, M.F. Preparation and Physiochemical Characterization of Bitter Orange Oil Loaded Sodium Alginate and Casein Based Edible Films. Polymers 2022, 14, 3855. [Google Scholar] [CrossRef]
- Jiang, Y.; Lan, W.; Sameen, D.E.; Ahmed, S.; Qin, W.; Zhang, Q.; Chen, H.; Dai, J.; He, L.; Liu, Y. Preparation and characterization of grass carp collagen-chitosan-lemon essential oil composite films for application as food packaging. Int. J. Biol. Macromol. 2020, 160, 340–351. [Google Scholar] [CrossRef]
- Guerra, I.C.; de Sousa, T.L.; de Farias, P.M.; Cappato, L.P.; de Freitas, B.S.M.; Romani, V.P.; Plácido, G.R. Films and coatings from pequi mesocarp incorporated with nano-ZnO: Properties and capacity to increase mango shelf life. Ind. Crops Prod. 2023, 195, 116414. [Google Scholar] [CrossRef]
- Guo, X.; Wang, X.; Wei, Y.; Liu, P.; Deng, X.; Lei, Y.; Zhang, J. Preparation and properties of films loaded with cellulose nanocrystals stabilized Thymus vulgaris essential oil Pickering emulsion based on modified tapioca starch/polyvinyl alcohol. Food Chem. 2024, 435, 137597. [Google Scholar] [CrossRef]
- Souza, A.G.; Ferreira, R.R.; Paula, L.C.; Mitra, S.K.; Rosa, D.S. Starch-based films enriched with nanocellulose-stabilized Pickering emulsions containing different essential oils for possible applications in food packaging. Food Packag. Shelf Life 2021, 27, 100615. [Google Scholar] [CrossRef]
- Filipini, G.d.S.; Romani, V.P.; Martins, V.G. Biodegradable and active-intelligent films based on methylcellulose and jambolão (Syzygium cumini) skins extract for food packaging. Food Hydrocoll. 2020, 109, 106139. [Google Scholar] [CrossRef]
- Basiak, E.; Debeaufort, F.; Lenart, A. Effect of oil lamination between plasticized starch layers on film properties. Food Chem. 2016, 195, 56–63. [Google Scholar] [CrossRef]
- Galus, S.; Kadzińska, J. Whey protein edible films modified with almond and walnut oils. Food Hydrocoll. 2016, 52, 78–86. [Google Scholar] [CrossRef]
- Liu, J.; Xu, Q.; Zhang, J.; Zhou, X.; Lyu, F.; Zhao, P.; Ding, Y. Preparation, composition analysis and antioxidant activities of konjac oligo-glucomannan. Carbohydr. Polym. 2015, 130, 398–404. [Google Scholar] [CrossRef]
- Tong, C.; Wu, Z.; Sun, J.; Lin, L.; Wang, L.; Guo, Y.; Huang, Z.; Wu, C.; Pang, J. Effect of carboxylation cellulose nanocrystal and grape peel extracts on the physical, mechanical and antioxidant properties of konjac glucomannan films. Int. J. Biol. Macromol. 2020, 156, 874–884. [Google Scholar] [CrossRef]
- Liu, N.; Yang, W.; Li, X.; Zhao, P.; Liu, Y.; Guo, L.; Huang, L.; Gao, W. Comparison of characterization and antioxidant activity of different citrus peel pectins. Food Chem. 2022, 386, 132683. [Google Scholar] [CrossRef]
- Kumar, A.; Lal, R.K. The consequence of genotype × environment interaction on high essential oil yield and its composition in clove basil (Ocimum gratissimum L.). Acta Ecol. Sin. 2022, 42, 633–640. [Google Scholar] [CrossRef]
- Silva, J.C.; Silva Pereira, R.L.; Sampaio de Freitas, T.; Rocha, J.E.; Macedo, N.S.; de Fatima Alves Nonato, C.; Linhares, M.L.; Tavares, D.S.A.; da Cunha, F.A.B.; Coutinho, H.D.M.; et al. Evaluation of antibacterial and toxicological activities of essential oil of Ocimum gratissimum L. and its major constituent eugenol. Food Biosci. 2022, 50, 102128. [Google Scholar] [CrossRef]
- Zong, X.; Zhang, X.; Bi, K.; Zhou, Y.; Zhang, M.; Qi, J.; Xu, X.; Mei, L.; Xiong, G.; Fu, M. Novel emulsion film based on gelatin/polydextrose/camellia oil incorporated with Lactobacillus pentosus: Physical, structural, and antibacterial properties. Food Hydrocoll. 2021, 121, 107063. [Google Scholar] [CrossRef]
- Pandey, S. Antibacterial and Antifungal Activities of Ocimum gratissimum L. Int. J. Pharm. Pharm. Sci. 2017, 9, 26–31. [Google Scholar] [CrossRef]
- Kanashiro, A.M.; Akiyama, D.Y.; Kupper, K.C.; Fill, T.P. Penicillium italicum: An Underexplored Postharvest Pathogen. Front. Microbiol. 2020, 11, 606852. [Google Scholar] [CrossRef] [PubMed]
- Marchese, A.; Barbieri, R.; Coppo, E.; Orhan, I.E.; Daglia, M.; Izadi, M.; Abdollahi, M.; Nabavi, S.M.; Ajami, M. Antimicrobial activity of eugenol and essential oils containing eugenol: A mechanistic viewpoint. Crit. Rev. Microbiol. 2017, 43, 668–689. [Google Scholar] [CrossRef] [PubMed]
- Li, Y.; Guo, L.; Zhou, Z. Exploring the antifungal mechanism of limonin-loaded eugenol emulsion against Penicillium italicum: From the perspective of microbial metabolism. Postharvest Biol. Technol. 2021, 182, 111704. [Google Scholar] [CrossRef]
- Kumar, A.; Pratap Singh, P.; Prakash, B. Unravelling the antifungal and anti-aflatoxin B1 mechanism of chitosan nanocomposite incorporated with Foeniculum vulgare essential oil. Carbohydr. Polym. 2020, 236, 116050. [Google Scholar] [CrossRef]
- Lou, S.; Ni, X.; Xiao, W.; Li, Y.; Gao, Z. Physical stability, microstructure and antimicrobial properties of konjac glucomannan coatings enriched with Litsea cubeba essential oil nanoemulsion and its effect on citruses preservation. Int. J. Biol. Macromol. 2024, 256, 128306. [Google Scholar] [CrossRef]
- Kumar, P.; Sethi, S.; Sharma, R.R.; Srivastav, M.; Varghese, E. Effect of chitosan coating on postharvest life and quality of plum during storage at low temperature. Sci. Hortic. 2017, 226, 104–109. [Google Scholar] [CrossRef]
- Zhao, J.; Wang, Y.; Li, J.; Lei, H.; Zhen, X.; Gou, D.; Liu, T. Preparation of chitosan/Enoki mushroom foot polysaccharide composite cling film and its application in blueberry preservation. Int. J. Biol. Macromol. 2023, 246, 125567. [Google Scholar] [CrossRef] [PubMed]
- Du, Y.; Shi, B.; Luan, X.; Wang, Y.; Song, H. Chitosan/cellulose nanocrystal biocomposite coating for fruit postharvest preservation. Ind. Crops Prod. 2023, 205, 117543. [Google Scholar] [CrossRef]
- Zhou, D.; Li, R.; Zhang, H.; Chen, S.; Tu, K. Hot air and UV-C treatments promote anthocyanin accumulation in peach fruit through their regulations of sugars and organic acids. Food Chem. 2020, 309, 125726. [Google Scholar] [CrossRef]
- He, Y.; Bose, S.K.; Wang, W.; Jia, X.; Lu, H.; Yin, H. Pre-Harvest Treatment of Chitosan Oligosaccharides Improved Strawberry Fruit Quality. Int. J. Mol. Sci. 2018, 19, 2194. [Google Scholar] [CrossRef] [PubMed]
- Khaliq, G.; Ramzan, M.; Baloch, A.H. Effect of Aloe vera gel coating enriched with Fagonia indica plant extract on physicochemical and antioxidant activity of sapodilla fruit during postharvest storage. Food Chem. 2019, 286, 346–353. [Google Scholar] [CrossRef] [PubMed]
- Nair, M.S.; Saxena, A.; Kaur, C. Effect of chitosan and alginate based coatings enriched with pomegranate peel extract to extend the postharvest quality of guava (Psidium guajava L.). Food Chem. 2018, 240, 245–252. [Google Scholar] [CrossRef] [PubMed]
- Jahani, R.; Behnamian, M.; Dezhsetan, S.; Karimirad, R.; Chamani, E. Chitosan nano-biopolymer/Citrus paradisi peel oil delivery system enhanced shelf-life and postharvest quality of cherry tomato. Int. J. Biol. Macromol. 2023, 225, 1212–1223. [Google Scholar] [CrossRef] [PubMed]
- Zhou, C.; Bai, J.; Zhang, F.; Zhang, R.; Zhang, X.; Zhong, K.; Yan, B. Development of mussel-inspired chitosan-derived edible coating for fruit preservation. Carbohydr. Polym. 2023, 321, 121293. [Google Scholar] [CrossRef]
- Zheng, Q.; Bai, X.; Chen, T.; Li, F.; Zhu, P.; Li, M.; Tang, Y. Carboxymethyl hemicellulose/sorbitol/gallic acid green composite films for fresh fruit preservation. Ind. Crops Prod. 2024, 218, 119013. [Google Scholar] [CrossRef]

| Sample | D[3,4] (μm) | D[2,3] (μm) | Span |
|---|---|---|---|
| P-OG 0.5% | 0.48 ± 0.22 a | 0.35 ± 0.29 a | 3.11 ± 0.19 c |
| P-OG 1.0% | 0.75 ± 0.03 b | 0.51 ± 0.04 b | 1.61 ± 0.10 b |
| P-OG 1.5% | 0.86 ± 0.04 b | 0.55 ± 0.02 b | 1.49 ± 0.02 b |
| P-OG 2.0% | 1.21 ± 0.07 c | 1.08 ± 0.15 c | 0.83 ± 0.31 a |
Disclaimer/Publisher’s Note: The statements, opinions and data contained in all publications are solely those of the individual author(s) and contributor(s) and not of MDPI and/or the editor(s). MDPI and/or the editor(s) disclaim responsibility for any injury to people or property resulting from any ideas, methods, instructions or products referred to in the content. |
© 2025 by the authors. Licensee MDPI, Basel, Switzerland. This article is an open access article distributed under the terms and conditions of the Creative Commons Attribution (CC BY) license (https://creativecommons.org/licenses/by/4.0/).
Share and Cite
Yu, X.; Zhu, J.; Wu, J.; Cheng, Y.; Gao, Y.; Liu, Y.; Jiang, F. Edible Coating Based on Konjac glucomannan Loading Ocimum gratissimum Essential Oil for Postharvest Preservation of Orange. Polymers 2025, 17, 1217. https://doi.org/10.3390/polym17091217
Yu X, Zhu J, Wu J, Cheng Y, Gao Y, Liu Y, Jiang F. Edible Coating Based on Konjac glucomannan Loading Ocimum gratissimum Essential Oil for Postharvest Preservation of Orange. Polymers. 2025; 17(9):1217. https://doi.org/10.3390/polym17091217
Chicago/Turabian StyleYu, Xiang, Jingyu Zhu, Jintao Wu, Yuhang Cheng, Ya Gao, Yi Liu, and Fatang Jiang. 2025. "Edible Coating Based on Konjac glucomannan Loading Ocimum gratissimum Essential Oil for Postharvest Preservation of Orange" Polymers 17, no. 9: 1217. https://doi.org/10.3390/polym17091217
APA StyleYu, X., Zhu, J., Wu, J., Cheng, Y., Gao, Y., Liu, Y., & Jiang, F. (2025). Edible Coating Based on Konjac glucomannan Loading Ocimum gratissimum Essential Oil for Postharvest Preservation of Orange. Polymers, 17(9), 1217. https://doi.org/10.3390/polym17091217

